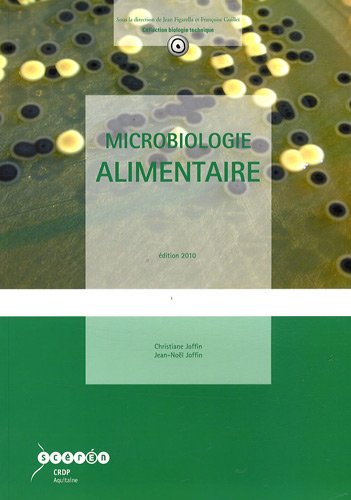
Microbiologie alimentaire

Chargement...
| Auteur(s) : | Christiane Joffin, Jean-Noël Joffin |
|---|---|
| Collection : | Collection biologie technique |
| Editeur : | SCÉRÉN-CRDP Aquitaine (FR Bordeaux) |
| Cette édition : | 2010 |
| Prix neuf : | 25.0 EUR |
| Code-barres : | 9782866175771 |
| Dimensions : | 30 cm |
| Volume : | 1 vol. (344 p.) |
| Autre : | ill. en noir et en coul., couv. ill. en coul. |